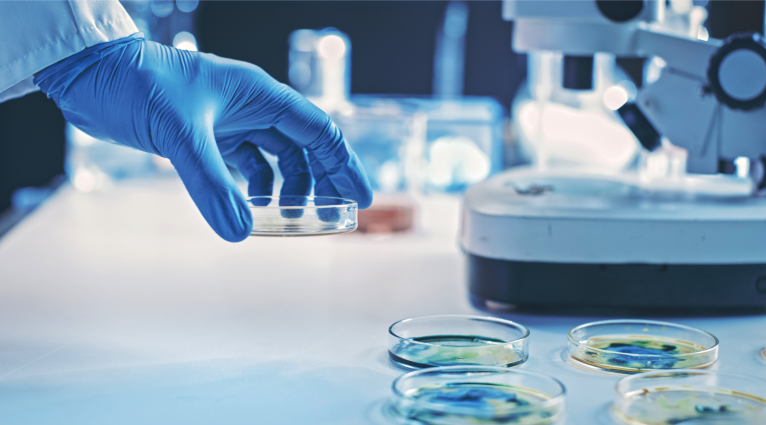

What Is eCOA? Improving Clinical Trial Data Quality
What is eCOA?
eCOA (Electronic Clinical Outcome Assessment) is a digital version of a COA (Clinical Outcome Assessment), which measures and records how a patient is feeling or functioning. It is used as part of a clinical trial to measure the efficacy of a health intervention.
eCOA is used in conjunction with quantitative clinical data to determine a patient’s experience with a disease and treatment more accurately. Measures used with eCOA are often in the form of questionnaires (e.g., rating of pain intensity, occurrence, and severity of migraines).
Deployed through various technologies including smartphones, tablets, computers, and interactive voice response systems, eCOAs allow patients, caregivers, and clinicians to report outcomes from clinical trials directly. Among the results are higher quality, granular data, and near real-time insights.
Considerations for eCOA Study Data Collection
- Adverse events that could provide insights into treatment tolerability
- Data criteria to be used for statistical datasets and sub-groups
- Data points to be used as primary or secondary endpoints, including applicable visits, visit schedule, safety, and efficacy assessments
- Inclusion and exclusion criteria
- Other prescription medications (e.g., over-the-counter [OTC] drugs, dietary supplements) that a patient takes in addition to the treatment under investigation.
- Tracking treatment recovery phases at home
- Trial objectives and design
eCOA Measures
eCOA measures take into account patients’ mental condition, symptoms of a disease, and the effect of a treatment on the patient’s function. An umbrella term, eCOA covers a variety of captured outcomes from clinical trials, including the following.
- Patient Reported Outcomes (PRO)
PRO is a measurement based on a report of the status of a patient’s health condition that comes directly from the patient—without amendment or interpretation of the patient’s response by a clinician or anyone else. An example is asking a patient, on a scale of 1-10, what is their level of pain today. - Clinical Reported Outcomes (ClinRO)
ClinRO is a measurement based on a report by a healthcare professional who observes the patient and records the clinical data. A ClinRO is the healthcare professional’s interpretation of a patient’s observable behavior or physical signs.
Take, for example, a patient with Alzheimer’s disease who is unable to report on their own. In this case, the healthcare provider would report the patient’s clinical outcomes. - Observer Reported Outcome (ObsRO)
ObsRO is a measurement based on a report of observable signs, events, or behaviors related to a patient’s health condition by someone other than the patient or a health professional. This observer could be a parent or other relative, caretaker, or friend.
The data that is reported does not include a medical judgment or interpretation. An ObsRO report is typically used when the patient cannot respond on their own, such as when the patient is unconscious, an infant, or mentally impaired. - Performance Outcomes (PerfO)
PerfO is a measurement based on data that is generated based on tasks that a patient performs according to instructions provided by a healthcare professional. An example of PerfO is performing memory recall or another cognitive test, used for patients with Alzheimer’s disease or dementia. - Electronic Patient-Reported Outcome (ePRO)
ePro is a measurement commonly used in decentralized clinical trials to assess the efficacy of a treatment. With ePRO, patients remotely send their symptoms and experience directly to site staff. ePro uses electronic devices to capture and transmit patient-reported data, such as dosage, timing, side effects, and symptoms.
eCOA Advantages
There are numerous advantages to using eCOA in clinical trials, including:
- Eliminates hidden costs related to paper records
- Enables implementation of branching logic and skip logic in questions to reduce the length of questionnaires
- Enhances operational efficiencies
- Gives patients and healthcare providers the flexibility of data completion from anywhere (e.g., home, clinic, hospital)
- Improves patient retention
- Increases data accuracy
- Increases patient willingness to answer sensitive questions that they otherwise may not be comfortable answering in person
- Makes regulatory compliance easier and better
- Minimizes the number of quality checks and verification throughout a study
- Provides real-time insights into study performance
- Reduces missing data by nudging users with reminders to complete their assessments
eCOA and FDA 21 CFR Part 11 Compliance
An important element of compliance with 21CRF Part 11 is to ensure that electronic records are supported with an audit trail, event location, user, timestamp, and an electronic signature. eCOA provides this information as related to the data captured and reports produced.
eCOA follows the ALCOA principles used by the FDA to define five mandatory data integrity attributes, including:
- Attributable
- Legible
- Contemporaneous
- Original
- Accurate
How eCOA Improves Clinical Data Quality
The increased communication between patients and clinical staff promoted by eCOA results in more patient reporting of events—which means more data. There are several ways how eCOA improves clinical data quality.
eCOA Prevents Inconsistent or Conflicting Data
Branching and logic sequences for data collection leads patients through the relevant question in a logical order that has been put in place according to the study protocol. Patients or observers are prevented from skipping questions or entering inconsistent or conflicting data.
Pre-defined response options also help with data consistency. And eCOA ensures that patients are asked the same questions in the same order at every visit—without bias, halo, error, leniency, variation, interpretation, or mood.
eCOA Eliminates Transcription Errors
eDiaries that are part of eCOA capture data directly into the trial management system. Inconsistencies, missing data, and other data quality issues are detected in real-time at data capture, eliminating the need to input them later (another opportunity for error).
eCOA Meets Global Regulatory Standards
Because eCOA data meets regulatory quality guidelines, meaning it is Attributable, Legible, Contemporaneous, Original, and Accurate (ALCOA), it is accepted by regulatory agencies. eCOA also enables accurate timestamping, which means it can be used to meet audit requirements.
Use eCOA to Improve Clinical Trial Data Quality
The intrinsic benefits of digitization of processes abound with eCOA. The sheer volume of clinical trial data that can be efficiently gathered with eCOA drives the results.
Patients, healthcare workers, and other caregivers more consistently and accurately record observations. And they stay engaged with the clinical trial in a more consistent way, which leads to more and better data.
But perhaps the most valuable benefit of eCOA is how it improves clinical data quality. This improvement has material results, including generating more meaningful study reports more quickly with less work.
Egnyte has experts ready to answer your questions. For more than a decade, Egnyte has helped more than 16,000 customers with millions of customers worldwide.
Last Updated: 24th October, 2021


